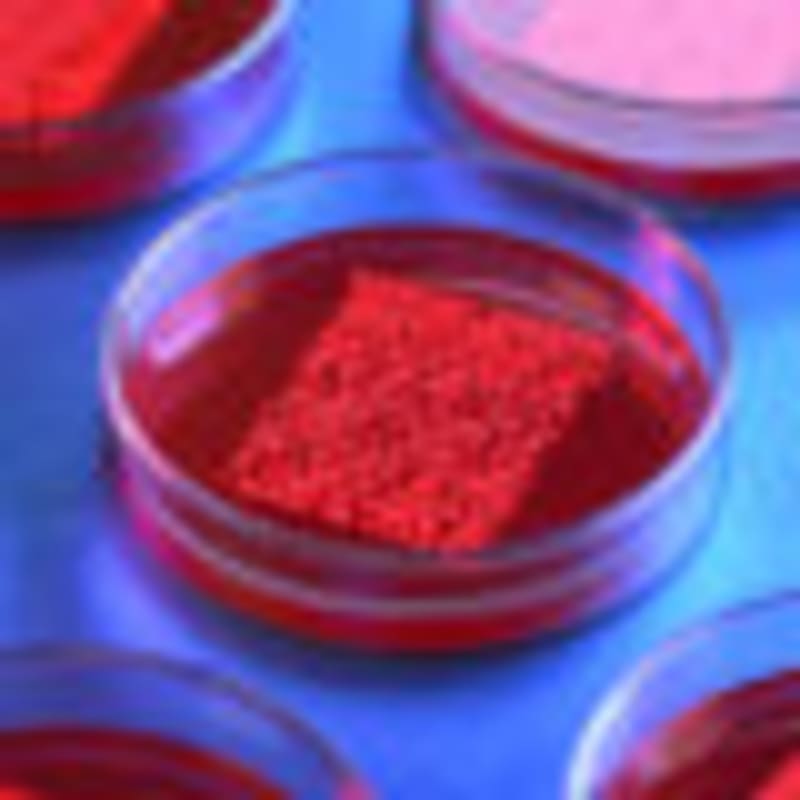
Congress Boosts NIH Budget $415M Despite Trump Cuts Plan - Image 3

Congress Boosts NIH Budget $415M Despite Trump Cuts Plan
Congressional leaders from both parties rejected President Trump's proposed cuts to the National Institutes of Health, instead boosting the research budget by $415 million for 2026. The bipartisan move protects funding for crucial medical research even as scientists face fewer grant awards overall.
After months of budget battles and the longest government shutdown in U.S. history, Congress delivered unexpected good news for medical research this week.
House and Senate appropriators agreed Tuesday to increase the National Institutes of Health budget to $48.7 billion for fiscal year 2026. That's a $415 million boost over last year, despite President Trump's push to downsize the agency.
The bipartisan spending bill represents a near-total rejection of White House proposals to reshape America's premier medical research institution. Lawmakers from both parties signaled strong support for protecting the agency that funds groundbreaking work on cancer, Alzheimer's, rare diseases, and countless other health challenges affecting millions of Americans.
Congress also preserved language designed to prevent the Trump administration from slashing support for research overhead. These funds help universities and research centers cover essential costs like lab equipment, facilities, and administrative support that make scientific discoveries possible.
The bill does include one concession to the White House. It allows continued use of a new funding strategy for multiyear grants that resulted in several thousand fewer awards for scientists in 2025, creating some uncertainty for researchers seeking longer-term support.

The Ripple Effect
This funding increase means more than numbers on a budget spreadsheet. Every dollar allocated to the NIH supports researchers working on treatments that could save lives, from developing new cancer therapies to understanding autism to creating vaccines for future pandemics.
The NIH funds over 300,000 researchers at more than 2,500 universities and research institutions nationwide. When Congress protects this funding, they're protecting jobs, supporting communities around research hubs, and investing in discoveries that benefit people worldwide.
The bipartisan support sends another powerful message. Even in deeply divided political times, lawmakers from both parties found common ground on supporting science and medical progress.
The measure still needs approval from the full House and Senate before heading to the president's desk. But legislators indicated they're eager to move forward after contentious budget negotiations that paralyzed parts of the federal government.
For the thousands of scientists whose work depends on NIH grants, and the millions of patients who benefit from their research, Congress chose hope over cuts.
More Images

Based on reporting by STAT News
This story was written by BrightWire based on verified news reports.
Spread the positivity! π
Share this good news with someone who needs it

